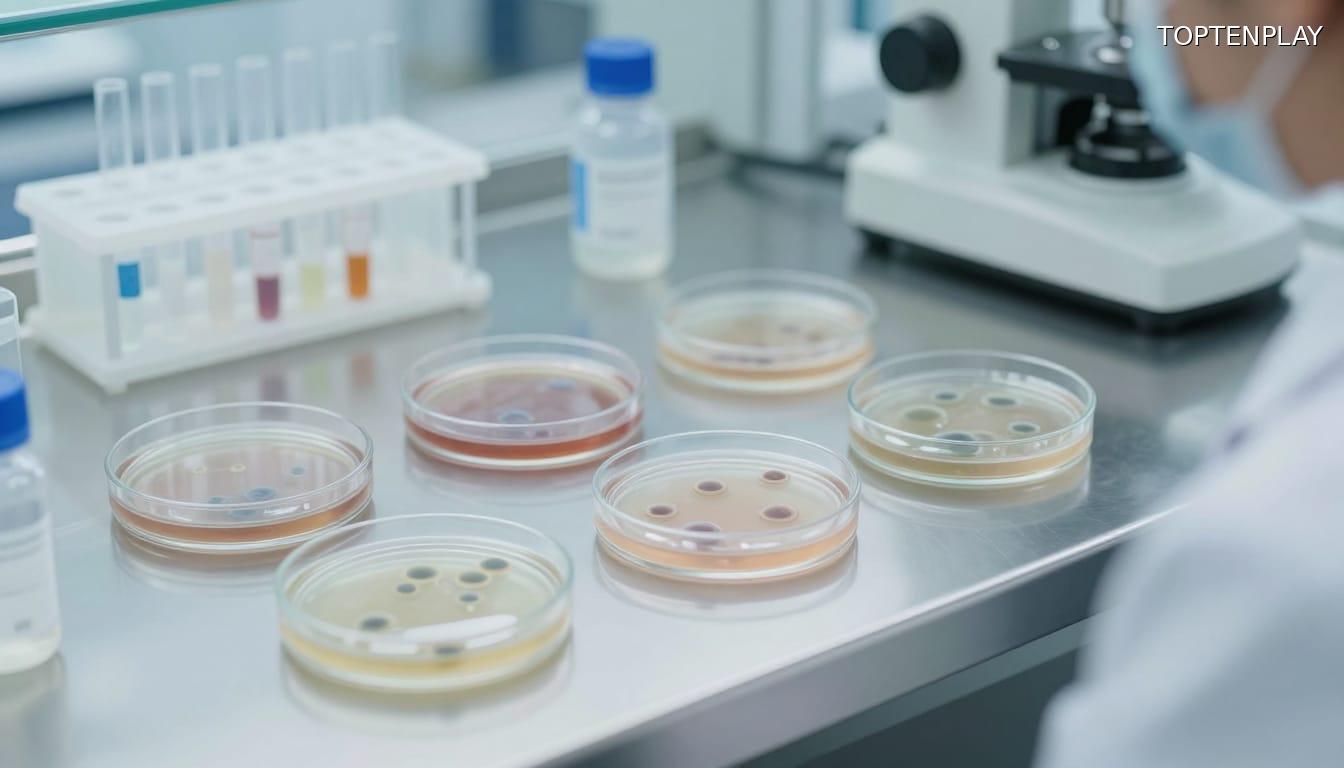
Image d'illustration © TopTenPlay

📌 E.Leclerc rappelle des Paris-Brest contaminés à la Listeria : voici les dates et le magasin concernés

Posted 2 mars 2026 by: Admin

Un Dessert Festif Sous Surveillance Sanitaire
Le Paris-Brest, cette pâtisserie à la crème pralinée prisée pour sa générosité, fait l’objet d’un rappel sanitaire dans l’Oise. L’hypermarché E.Leclerc du Plessis-Belleville a commercialisé entre le 14 et le 17 février 2026 un lot contaminé par la bactérie Listeria monocytogenes.
Le produit concerné se présente sous forme de barquette plastique transparente contenant deux Paris-Brest, issue de la fabrication interne du magasin. Son identification reste précise : GTIN 0202211025586, avec une date limite de consommation fixée au 17 février 2026. Cette référence unique permet aux consommateurs de vérifier rapidement s’ils détiennent le dessert visé.
Ce rappel cible exclusivement l’hypermarché situé au Centre commercial Les Portes du Valois, dans le département 60. Aucun autre établissement E.Leclerc n’est concerné par cette procédure. Les clients ayant fréquenté ce magasin durant les quatre jours de commercialisation doivent impérativement contrôler le contenu de leur réfrigérateur.
La découverte de la contamination bactérienne lors des contrôles réglementaires a déclenché une alerte immédiate. La présence de Listeria dans un produit frais consommé sans cuisson ultérieure représente un risque sanitaire nécessitant une vigilance accrue.
Listeria Monocytogenes : La Bactérie Derrière Le Rappel
La contamination détectée lors des contrôles réglementaires révèle la présence de Listeria monocytogenes, une bactérie pathogène responsable de la listériose. Cette infection alimentaire ne se manifeste pas immédiatement : son délai d’incubation peut s’étendre jusqu’à huit semaines après la consommation du produit contaminé.
Les premiers symptômes se traduisent généralement par une fièvre isolée, accompagnée de maux de tête persistants et de courbatures diffuses. Certains cas présentent également des troubles digestifs tels que nausées ou diarrhée, rendant le diagnostic initial parfois complexe. Cette symptomatologie variable explique pourquoi la listériose reste sous-diagnostiquée en phase précoce.
Les personnes âgées, les immunodéprimés et les femmes enceintes constituent les publics les plus vulnérables face à cette bactérie. Chez ces populations fragiles, l’infection peut évoluer vers des formes neurologiques sévères ou provoquer des complications fœtales graves. La vigilance s’impose donc particulièrement pour ces groupes à risque.
La particularité de cette contamination réside dans sa temporalité : contrairement aux intoxications alimentaires classiques qui se déclarent en quelques heures, la listériose impose une surveillance prolongée sur plusieurs semaines. Cette fenêtre d’observation étendue nécessite une traçabilité précise des consommations et une sensibilisation accrue aux signaux d’alerte corporels, même tardifs.

Marche À Suivre Pour Les Consommateurs
Face à cette contamination confirmée, la première mesure consiste à vérifier immédiatement le contenu du réfrigérateur. Tout Paris-Brest acheté entre le 14 et le 17 février 2026 au magasin E.Leclerc du Plessis-Belleville doit être identifié et isolé sans délai.
Deux options s’offrent aux détenteurs du produit rappelé : la destruction directe du dessert ou son retour en magasin. Le remboursement est garanti pour tout produit rapporté à l’hypermarché concerné, situé au Centre commercial Les Portes du Valois. Cette démarche reste possible jusqu’au 17 avril 2026, offrant un délai de deux mois pour effectuer le retour.
Pour toute question relative aux modalités pratiques du rappel ou du remboursement, le magasin met à disposition un numéro de contact dédié : 03 44 60 71 46. Ce service permet d’obtenir des précisions sur la procédure et de lever les éventuelles incertitudes concernant l’identification du lot.
L’essentiel réside dans la réactivité : chaque jour de conservation supplémentaire du produit contaminé augmente le risque d’oubli et de consommation accidentelle. La traçabilité de cet achat alimentaire devient capitale, d’autant que la période d’incubation prolongée de la listériose impose une vigilance sanitaire sur plusieurs semaines. Cette rigueur dans la gestion du rappel conditionne directement la prévention des complications ultérieures.

Surveillance Médicale Recommandée
Au-delà du retour produit, la vigilance sanitaire s’impose pour toute personne ayant consommé ce Paris-Brest. La particularité de la listériose réside dans sa période d’incubation silencieuse, s’étendant parfois jusqu’à huit semaines après ingestion. Cette latence prolongée exige une surveillance active de tout symptôme inhabituel : fièvre inexpliquée, maux de tête persistants, courbatures diffuses.
Face à l’apparition de ces manifestations, la consultation médicale devient impérative. Un détail déterminant : mentionner explicitement au praticien la consommation du dessert rappelé. Cette information oriente immédiatement le diagnostic vers une possible contamination bactérienne et permet d’initier, si nécessaire, un traitement antibiotique adapté avant l’aggravation des symptômes.
Les publics fragiles doivent redoubler de précaution. Femmes enceintes, personnes âgées et immunodéprimées s’exposent à des complications graves, pouvant évoluer vers des atteintes neurologiques ou des septicémies. Pour ces profils à risque, toute fièvre survenant dans les deux mois suivant la consommation justifie une consultation médicale immédiate, même en l’absence d’autres signes.
Cette traçabilité médicale transforme un simple rappel produit en dispositif de santé publique. L’information transmise au médecin, combinée à la chronologie de consommation, constitue la clé d’une prise en charge précoce et efficace face aux risques réels de la listériose.




















